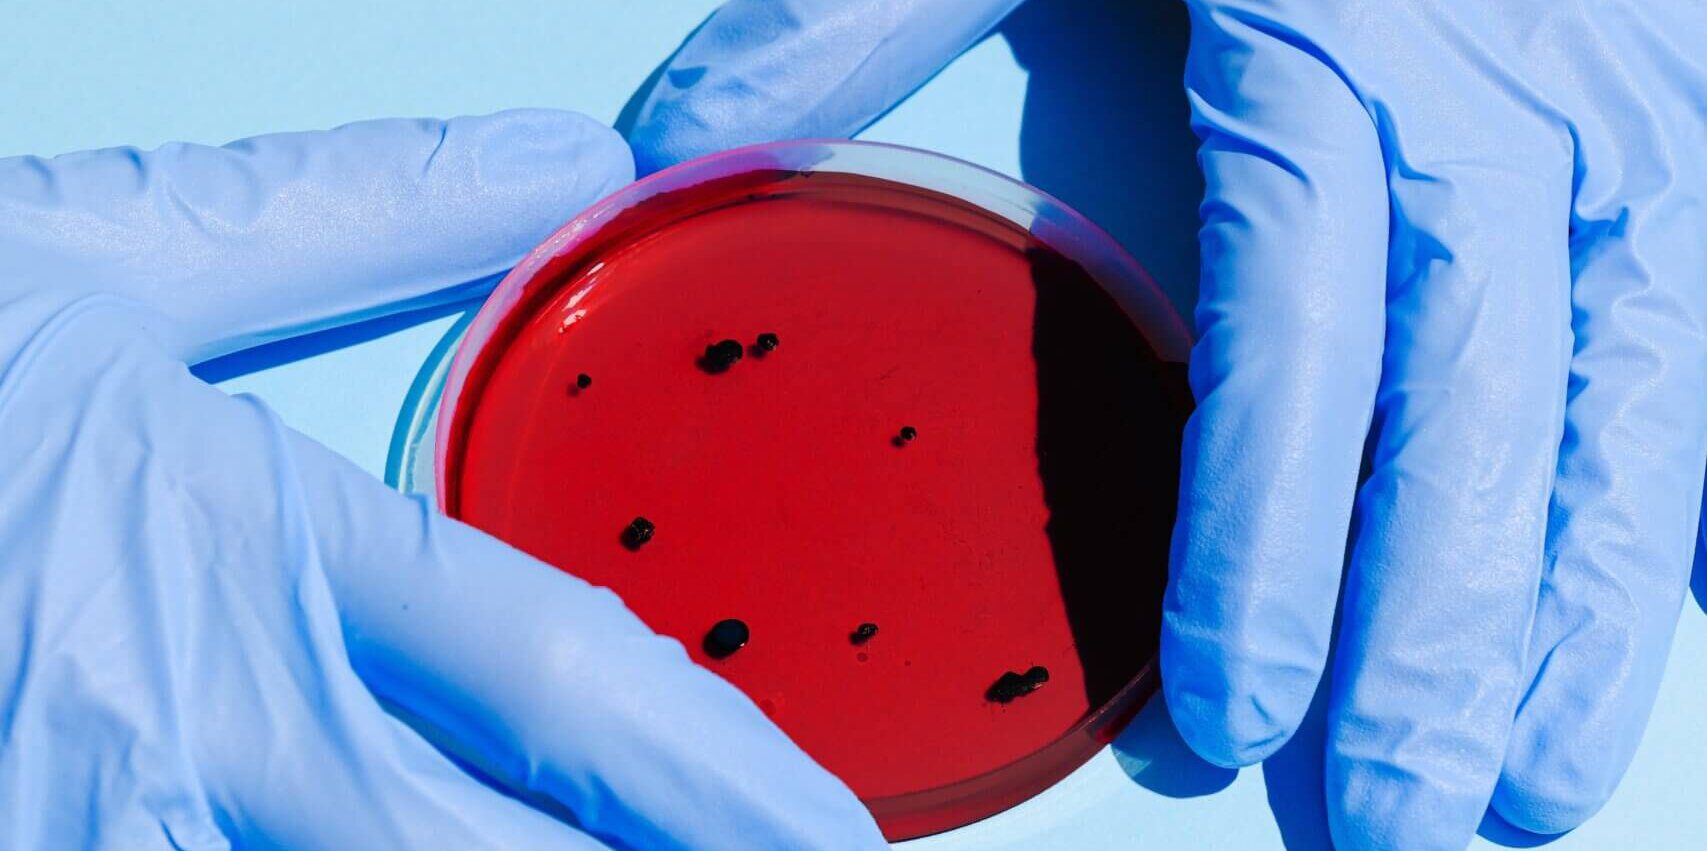
CDC Study Highlights Need for Ongoing Monitoring to Identify Emergence of Antibiotic-Resistant Bacteria in Community Settings

First-of-its-kind population-level analysis finds 10% of individuals with carbapenem-resistant Enterobacterales had no healthcare exposure
Arlington, Va., July 28, 2022 – A study led by researchers at the U.S. Centers for Disease Control and Prevention (CDC) suggests that ongoing population-based surveillance is critical to monitor for the emergence of carbapenem-resistant Enterobacterales (CRE) outside of traditional healthcare settings. Published today in the American Journal of Infection Control (AJIC), the study found that a small but notable proportion of CRE cases, a type of bacteria that can cause severe and difficult-to-treat infections, occurs in individuals who are not known to have traditional healthcare risk factors.
CRE are an important cause of multidrug-resistant infections and can spread rapidly, contributing to their classification by CDC as an urgent U.S. public health threat. Additionally, some CRE produce a carbapenemase gene that can be shared between different bacteria, accelerating the spread of resistance and the risk for hard-to-treat infections. Traditionally, patients that become infected with CRE have an ongoing healthcare exposure or a history of it, such as hospitalizations or stays in long-term care facilities. However, cases of CRE without healthcare risk factors have emerged in recent years. The study published today represents the first population-level description of such community-associated (CA) CRE in the United States.
“While only 10% of the CRE cases in our study were determined to be community-associated, this finding, coupled with the fact that five of 12 CRE isolates we sequenced had carbapenemase genes is concerning,” said Sandra Bulens, MPH, health scientist in CDC’s Division of Healthcare Quality Promotion, and lead author on the study. “Further investigation is needed to understand this emergence in the community and how infection prevention and control efforts can be targeted to reduce spread.”
Previous reports have suggested that international travel, previous antibiotic use, or contact with family members who frequently receive treatment or visit healthcare facilities may play a role in CA-CRE cases.
The current study used data obtained from eight U.S. metropolitan areas between January 2012 and December 2015 as part of CDC’s Emerging Infections Program (EIP) Healthcare-Associated Infections – Community Interface Activity, which has conducted laboratory- and population-based surveillance for CRE and other drug-resistant gram-negative bacteria since 2011. Researchers identified patients diagnosed with CRE, and then compared the incidence and epidemiology of CA-CRE cases to CRE cases with healthcare risk factors. Cases were classified as CA-CRE if they had no known healthcare risk factors, based on medical record review, and a culture collected <3 days after hospital admission.
In total, researchers identified 1,499 CRE cases among 1,194 patients with documented CRE. Among these, 149 CRE cases (10%) were classified as community associated. The incidence of CRE cases per 100,000 population was 2.96 (95% CI: 2.81, 3.11) overall and 0.29 (95% CI: 0.25, 0.25) for CA-CRE. Most CA-CRE cases were in White persons (73%) and females (84%).
As part of the study, researchers performed whole genome sequencing on a subset of CRE isolates. Among the 12 sequenced CA-CRE isolates, 5 (42%) harbored a carbapenemase gene. Preventing the spread of these carbapenemases is critical because they are resistant to some newer antibiotics.
“This study provides important initial data regarding the potential for CRE to become more common in the community,” said Linda Dickey, RN, MPH, CIC, FAPIC, 2022 APIC president. “It also reinforces the need for continued CRE monitoring outside of healthcare settings to inform community infection-prevention efforts and reduce the spread of serious, drug-resistant infections.”
More information on preventing the spread of CRE can be found at CDC’s website: https://www.cdc.gov/hai/organisms/cre/index.html.
About APIC
Founded in 1972, the Association for Professionals in Infection Control and Epidemiology (APIC) is the leading association for infection preventionists and epidemiologists. With more than 15,000 members, APIC advances the science and practice of infection prevention and control. APIC carries out its mission through research, advocacy, and patient safety; education, credentialing, and certification; and fostering development of the infection prevention and control workforce of the future. Together with our members and partners, we are working toward a safer world through the prevention of infection. Join us and learn more at apic.org.
About AJIC
As the official peer-reviewed journal of APIC, The American Journal of Infection Control (AJIC) is the foremost resource on infection control, epidemiology, infectious diseases, quality management, occupational health, and disease prevention. Published by Elsevier, AJIC also publishes infection control guidelines from APIC and the CDC. AJIC is included in Index Medicus and CINAHL. Visit AJIC at ajicjournal.org.
NOTES FOR EDITORS
“Carbapenem-Resistant enterobacterales in individuals with and without health care risk factors—Emerging infections program, United States, 2012-2015,” by Sandra Bulens, MPH, and colleagues, was published online in AJIC on July 28, 2022. The article may be found online at: https://doi.org/10.1016/j.ajic.2022.04.003
LEAD AUTHOR
Sandra Bulens, MPH (sbulens@cdc.gov)
Centers for Disease Control and Prevention
Atlanta, GA, USA